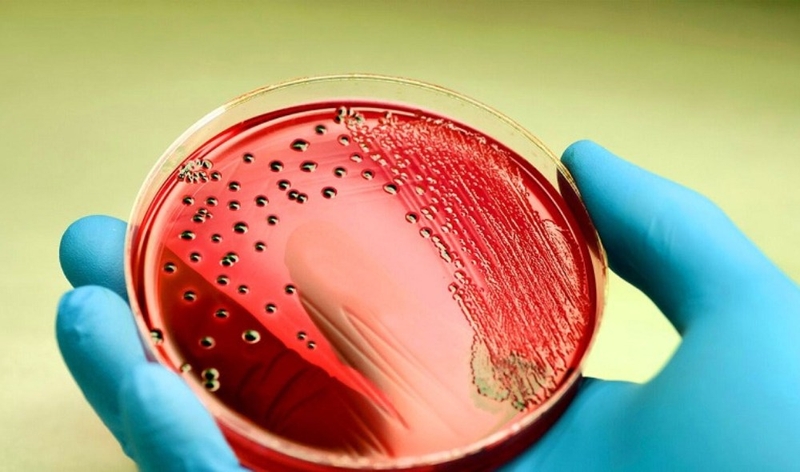
Gan to ở trẻ em là bệnh gì và cách chẩn đoán 4

Dược sĩ Đại học có nhiều năm kinh nghiệm trong việc tư vấn Dược phẩm và hỗ trợ giải đáp thắc mắc về Bệnh học. Hiện đang là giảng viên cho Dược sĩ tại Nhà thuốc Long Châu.
Gan to ở trẻ em là bệnh gì và cách chẩn đoán
Thùy Hương
27/10/2023
Mặc định
Lớn hơn
Gan to ở trẻ em là một tình trạng bất thường, dấu hiệu cảnh báo nhiều bệnh lý nghiêm trọng. Vậy nguyên nhân gan to là gì, chẩn đoán như thế nào?
Gan to ở trẻ em là một vấn đề y tế quan trọng mà các bậc cha mẹ luôn quan tâm. Sự tăng kích thước của gan ở trẻ nhỏ không chỉ là một dấu hiệu cần chú ý, mà còn có thể là tín hiệu của những bệnh lý nghiêm trọng. Hãy cùng Nhà thuốc Long Châu tìm hiểu kĩ hơn về nguyên nhân, dấu hiệu và cách chẩn đoán gan to ở trẻ nhỏ trong bài viết dưới đây.
Bệnh gan to là gì?
Gan là một cơ quan quan trọng tham gia vào quá trình tiêu hóa và thực hiện nhiều chức năng quan trọng khác trong cơ thể. Nó thực hiện việc sản xuất mật để giúp tiêu hóa thức ăn trong dạ dày, chuyển chúng thành năng lượng và đồng thời còn tạo ra các hormone và loại bỏ các độc tố từ máu, bao gồm cả việc kiểm soát, sản xuất, và chuyển hóa các chất béo.
Gan to là tình trạng khi kích thước của gan tăng lên. Trong một số trường hợp, cả gan và lá lách có thể tăng kích thước, được gọi chung là gan lách to.
Tình trạng gan to có thể là dấu hiệu và triệu chứng của một loạt bệnh lý, bao gồm bệnh gan, suy tim sung huyết, hoặc ung thư gây ra. Điều quan trọng trong việc điều trị là xác định nguyên nhân cụ thể gây ra tình trạng gan to và kiểm soát các yếu tố gốc của nó.

Nguyên nhân gây gan to ở trẻ em
Có nhiều nguyên nhân gây ra tình trạng gan to ở trẻ em, và tác động của nó đến sức khỏe của trẻ phụ thuộc vào nguyên nhân cụ thể. Dưới đây là một số nguyên nhân phổ biến gây ra bệnh gan to ở trẻ sơ sinh và trẻ nhỏ:
- Nhiễm trùng gây gan to: Một loạt các virus và vi trùng có thể gây viêm gan và dẫn đến tình trạng gan to. Các ví dụ bao gồm viêm gan siêu vi A, B, C, D, E, CMV và Herpes Simplex, cũng như nhiễm trùng huyết, Leptospirose, giang mai, ký sinh trùng như sốt rét, Toxoplasma, Histoplasma và giun sán, cũng như nấm Actinomyces và Cryptococcosis.
- Bệnh lý tim mạch: Các bệnh như viêm màng ngoài tim co thắt, huyết khối tĩnh mạch gan, hội chứng Budd - Chiari và nghẽn tĩnh mạch chủ trên hoặc mạng lưới tĩnh mạch trong gan có thể gây ra tình trạng gan to ở trẻ nhỏ.
- Suy tim: Suy tim có thể gây ra sự suy yếu trong quá trình tuần hoàn máu, tạo áp lực lên tĩnh mạch cửa, một tĩnh mạch quan trọng cung cấp máu cho gan.
- Bệnh huyết học gây gan to: Các bệnh huyết học như thiếu máu tan máu do nhiều nguyên nhân khác nhau có thể gây ra tình trạng gan to ở trẻ nhỏ.
- Ung thư gan: Ung thư gan có thể xuất phát từ gan (ung thư gan nguyên phát) hoặc lan từ các cơ quan khác trong cơ thể (ung thư gan thứ phát). Cả hai loại ung thư này đều có thể gây gan to.
- Bệnh chuyển hóa: Các bệnh như bệnh Wilson, bệnh tích tụ glycogen, thiếu alpha-1 antitrypsin, mucolipidosis, hay mucopolysaccharide cũng có thể gây ra tình trạng gan to ở trẻ sơ sinh và trẻ nhỏ.
- Bất thường về giải phẫu gan: Các bất thường về giải phẫu học như teo hẹp đường mật, u nang ống mật chủ, sỏi mật có thể dẫn đến tình trạng gan to.
- Chấn thương gan: Chấn thương gan có thể gây ra máu tụ hoặc viêm gan nhiễm độc do sử dụng các chất như Acetaminophen, sắt (Fe), vitamin A hoặc chất độc.
- Gan nhiễm mỡ: Trẻ bị gan nhiễm mỡ có thể do suy dinh dưỡng hoặc thiếu vitamin, điều này cũng có thể dẫn đến tình trạng gan to.
Sự hiểu biết về nguyên nhân cụ thể của tình trạng gan to là quan trọng để xác định và điều trị tình trạng này hiệu quả.

Cách chẩn đoán gan to ở trẻ nhỏ
Chẩn đoán gan to ở trẻ em một cách kịp thời đóng vai trò quan trọng trong việc đưa ra phác đồ điều trị chính xác và hiệu quả. Các phương pháp chẩn đoán gan to ở trẻ em bao gồm:
Chẩn đoán dựa trên biểu hiện lâm sàng
Một số biểu hiện thường gặp ở chứng gan to trên trẻ nhỏ như:
- Trẻ thường có các triệu chứng như đau bụng, đau âm ỉ ở vùng nửa bên phía trên bên phải của bụng. Trẻ nhỏ có thể thể hiện sự không thoải mái bằng cách quấy khóc, trong khi trẻ lớn hơn có thể phàn nàn về đau.
- Trẻ thường trở nên chán ăn, không thích ăn, dẫn đến tình trạng mệt mỏi.
- Có thể xuất hiện những triệu chứng khác như đau nhức cơ, vàng da, vàng mắt, nước tiểu có màu vàng đậm và phân bạc màu.
- Sự xuất hiện của tình trạng xuất huyết dưới da và chảy máu chân răng cũng có thể là dấu hiệu.

Các xét nghiệm
Bác sĩ có thể yêu cầu làm một số xét nghiệm để chẩn đoán gan to ở trẻ em:
- Đối với viêm gan Wilson, chẩn đoán thường dựa trên đo lượng đồng trong máu và ceruloplasmin trong máu của trẻ.
- Trong trường hợp nghi ngờ về nhiễm trùng, các xét nghiệm như cấy máu, huyết đồ, CRP (chỉ số tụ cầu phản ứng), và xét nghiệm huyết thanh có thể được thực hiện dựa trên nguyên nhân cụ thể.
- Nếu có nghi vấn về nghẽn đường mật, các chỉ số như Bilirubin, PAL (phosphatase alkali) và gamma GT có thể tăng cao.
- Kiểm tra nếu có vấn đề về tạo máu ngoài tủy, xét nghiệm huyết đồ, hình dạng hồng cầu, men hồng cầu, và bilirubin thường được thực hiện.
- Nếu thời gian đông máu kéo dài, NH3 (ammonia) trong máu tăng lên và chỉ số albumin trong máu giảm, có thể là dấu hiệu của suy gan.
- Tăng ALT và AST trong máu có thể gợi ý tổn thương tế bào gan cấp tính.
Tình trạng gan to ở trẻ em có thể xuất phát từ các bệnh lý nghiêm trọng, do đó, việc không điều trị kịp thời và theo đúng phác đồ có thể dẫn đến những biến chứng nguy hiểm như bệnh não gan, suy gan, ung thư lan tỏa hoặc nhiễm trùng lan rộng.
Xem thêm: Gan thô có nguy hiểm không? Phương pháp phòng ngừa
Các bài viết liên quan
Gan nhiễm mỡ độ 4 sống được bao lâu? Cách kéo dài tuổi thọ
Xơ hóa gan F1 là gì? Có nguy hiểm không và cách kiểm soát hiệu quả
5 dấu hiệu trên da cảnh báo bệnh gan bạn không nên bỏ qua
Xơ gan F1 có chữa được không? Những cách kiểm soát để tránh tiến triển nặng
Liệu uống nước chanh có tốt cho gan không? Khi uống cần lưu ý gì?
[Infographic] Thực phẩm tốt cho gan mỗi ngày!
Uống thuốc huyết áp có ảnh hưởng đến gan không? Những tác dụng phụ cần lưu ý
Bị viêm gan B sống được bao lâu nếu phát hiện và điều trị sớm?
Viêm gan A lây qua đường nào và các biện pháp phòng ngừa cần thiết
4 dấu hiệu sau bữa ăn cảnh báo gan nhiễm mỡ
:format(webp)/Option_1_2_2d9677e5fd.png)
:format(webp)/Option_1_1_2a84e0cd00.png)
:format(webp)/ds_my_huyen_780f9bef46.png)